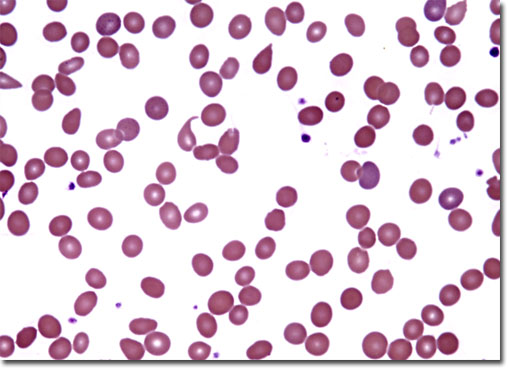

أنيميا التحلل الدموي
فقر الدم الإنحلالي
Hemolytic Anemia
تتميز أنيميا التحلل الدموي بحدوث تحلل للدم، وهو التحطيم السابق لأوانه لخلايا
الدم الحمر. ثمة أنواع كثيرة من أنيميا التحلل الدموي الوراثية والمكتسبة.
كما في أنواع الأنيميا الأخرى، فإن النتيجة النهائية لأنيميا التحلل الدموي هي
حدوث انخفاض في الهيموجلوبين، وهو البروتين الحامل للاكسجين داخل خلايا الدم الحمر.
إذا تحطمت الخلايا قبل أوانها، فإن الجسم ينتج خلايا دم جديدة لتعويض ما فقد منها.
تحدث الأنيميا عندما يتجاوز معدل تحطيم الخلايا قدرة نخاع العظام على إنتاج خلايا
دم جديدة.
الأسباب
ثمة أسباب كثيرة لأنيميا التحلل الدموي. بعض الأشكال الوراثية منها، تتميز بغشاء
غير طبيعي لخلية الدم الحمر متصلب وهش، مما يجعل الخلايا الحمر تحتجز بسهولة في
الأوعية الدقيقة بالطحال حيث يتم تكسيرها بأعداد كبيرة. في حالة فرط تكور الخلايا
(وهي مشكلة وراثية تتعلق بغشاء خلية الدم الحمراء)، توجد خلايا دم حمر عديدة صغيرة
الحجم
ومكورة الشكل وهشة سهلة التكسر.
فى الأشكال الوراثية الأخرى يوجد نقص في إنزيم معين تحتاجه خلايا الدم الحمر،
وهو جلوكوز 6 فوسفات ديهيدروجيناز G6PD. هذا النقص يجعل الخلايا تنفجر وتموت في
وجود مواد معينة مما يؤدي إلى الأنيميا.
يؤثر نقص هذا الإنزيم على حوالي 15% من الرجال السود في الولايات المتحدة.
ثمة أدوية مثل بعض المضادات الحيوية أو عقاقير مركبات الكينين المستخدمة لعلاج
الملاريا تسبب تحلل خلايا الدم الحمر في من يعانون نقصا في إنزيم G6PD.
هناك عدد قليل من الأشخاص الذين ينتمون إلى أصول من منطقة البحر المتوسط ويعانون
من نقصاً في إنزيم G6PD يتفاعلون تجاه مادة في الفول فيصابون بحالة تسمى أنيميا
الفول، وهي من حالات أنيميا التحلل الدموي الناتجة عن زيادة تكسير خلايا الدم
الحمر. وهي أيضا حالة وراثية.
أما أنيميا التحلل الدموي المكتسبة فلا تتسبب عن تغيرات موروثة في الخلايا نفسها،
ولكن تنتج عن قوى خارجية. فمن أمثلتها الملاريا التي تقوم فيها كائنات حية دقيقة
بإصابة خلايا الدم الحمر بالعدوى ثم تعمل على تدمير تلك الخلايا وإصابتها بالتحلل.
هناك مثال أخر هو نتيجة للإصابة الفيزيائية التي تحدث عندما يتدفق الدم من خلال
صمام صناعي. إذ تتلقى خلايا الدم الحمر السليمة صدمات متلاحقة في تلك الحالات ويصاب
بعضها بالتكسر والتحلل.
في بعض الناس قد يحدث مرض من أمراض المناعة الذاتية يجعل الجسم يتعامل بشكل خاطئ
مع خلايا دمه الحمر على أنها غريبة عنه فيقتلها.
أنيميا التحلل الدموي الناتجة عن تفاعل مناعي يمكن أن تحدث أيضا عندما يتم نقل دم
غير متوافق إلى مجرى دم الشخص المتلقي.
في أنيميا التحلل الدموي في حديثي الولادة نجد جهاز المناعة للأم يدمر خلايا الدم
الحمر لجنينها.
الأعراض
إن أعراض أنيميا التحلل الدموي تكون في الغالب مماثلة للأنواع الأخرى من الأنيميا
وتشمل الشحوب والإعياء والصداع وقصر الأنفاس وسرعة دقات القلب. مع ذلك فإن اصفرار
الجلد واصفرار بياض العينين (وهي الحالة التى تسمى اليرقان) تكون علامة أكثر
تمييزاً لأنيميا التحلل الدموي، فهي تعكس حالة من ارتفاع تركيز الأصباغ ذات اللون
البني المصفر التي تنطلق في الدم عندما يحدث تكسير للخلايا الحمر. يمكن أن يصبح
البول داكن اللون بسبب إخراج تلك الأصباغ في البول.
خيارات العلاج
يمكن تقييم حالة أنيميا التحلل الدموي بفحص مسحة دم.
مسحة الدم تكشف غالبا عن وجود أعداد كبيرة في خلايا دم حمر غير ناضجة، كما تكشف –
في بعض صور أنيميا التحلل الدموي- عن خلايا غريبة الشكل.
هناك بعض اختبارات الدم التخصصية التي تكون ضرورية لتأكيد التشخيص وتحديد السبب.
واجب الطبيب أن يعالج الحالة المسببة كخطوة أولى في تصحيح حالتك المرضية. فمثلا
يمكن السيطرة على اضطرابات المناعة الذاتية باستخدام العقاقير المثبطة للمناعة.
الأشخاص الذين يعانون نقص إنزيم G6PD يجب عليهم تنبيه من يعالجهم من الأطباء بألا
يصفوا لهم أدوية يمكن أن تسبب تكسيرا لخلايا الدم الحمر.
بعض الأشكال الوراثية من أنيميا التحلل الدموي تعالج بالاستئصال الجراحي للطحال
(وهو العضو الذي يتم فيه تكسير خلايا الدم الحمر).